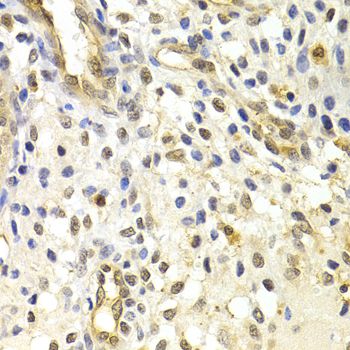

Filters
Clonality
Type
Reactivity
Gene Name
Isotype
Host
Application
Clone
725 results for " Protein S" - showing 150-200
MCAM, Monoclonal Antibody (Cat# AAA14131)
protein disulfide isomerase family A, member 3, ELISA Kit (Cat# AAA15047)
SPAM1, Polyclonal Antibody (Cat# AAA29645)
amyloid beta (A4) precursor protein, ELISA Kit (Cat# AAA18393)
COVID 19 Coronavirus, Reagent (Cat# AAA13552)
SEPT7, Polyclonal Antibody (Cat# AAA10767)
STIP1, Monoclonal Antibody (Cat# AAA26141)
Complement C3, ELISA Kit (Cat# AAA10791)
Fibrinogen beta, ELISA Kit (Cat# AAA16173)
Atrial Natriuretic Peptide, Monoclonal Antibody (Cat# AAA26703)
Atrial Natriuretic Peptide, Monoclonal Antibody (Cat# AAA26705)
Atrial Natriuretic Peptide, Monoclonal Antibody (Cat# AAA26710)
Atrial Natriuretic Peptide, Monoclonal Antibody (Cat# AAA26706)
Alpha-1-acid glycoprotein 1 (ORM1), ELISA Kit (Cat# AAA27211)
Atrial Natriuretic Peptide, Monoclonal Antibody (Cat# AAA26712)
Phosphatidylethanolamine Binding Protein 1 (PEBP1), ELISA Kit (Cat# AAA13933)
CDC2, Monoclonal Antibody (Cat# AAA26323)
Heat Shock 70kDa Protein 8 (HSPA8), ELISA Kit (Cat# AAA20685)
CDC2, Monoclonal Antibody (Cat# AAA26589)
Microsomal Glutathione S Transferase 1, Polyclonal Antibody (Cat# AAA20838)
pyruvate kinase, muscle, ELISA Kit (Cat# AAA14969)
Rad50, Polyclonal Antibody (Cat# AAA10640)
CDC2, Monoclonal Antibody (Cat# AAA26021)
ENO1, Polyclonal Antibody (Cat# AAA22202)
STRN3, Polyclonal Antibody (Cat# AAA28082)
PPP1CB, Monoclonal Antibody (Cat# AAA14154)
Glucose regulated protein 78, ELISA Kit (Cat# AAA16713)
DPP4, ELISA Kit (Cat# AAA21974)
TRMT2A, Polyclonal Antibody (Cat# AAA28127)
CHST2, Polyclonal Antibody (Cat# AAA23524)
Fatty Acid Binding Protein 4, Adipocyte (FABP4), ELISA Kit (Cat# AAA20483)
PSMC6, Polyclonal Antibody (Cat# AAA29708)
Ubiquitin Carboxyl Terminal Hydrolase L1 (UCHL1), ELISA Kit (Cat# AAA23063)
TXNL1, Polyclonal Antibody (Cat# AAA10784)
CDC5L, Monoclonal Antibody (Cat# AAA30247)
PITPNA, Monoclonal Antibody (Cat# AAA24614)
PHB, Monoclonal Antibody (Cat# AAA24904)
GSTZ1, Monoclonal Antibody (Cat# AAA25413)
CA1, Monoclonal Antibody (Cat# AAA24742)
CDC2, Monoclonal Antibody (Cat# AAA26287)
ATP5B, Polyclonal Antibody (Cat# AAA28083)
PHB, Monoclonal Antibody (Cat# AAA25791)
GSTZ1, Monoclonal Antibody (Cat# AAA24527)
Pyruvate Kinase, Muscle (PKM2), ELISA Kit (Cat# AAA13913)
GSTZ1, Monoclonal Antibody (Cat# AAA25708)
PHB, Monoclonal Antibody (Cat# AAA25495)
MTR4, Polyclonal Antibody (Cat# AAA29668)
Hepatocyte Growth Factor (HGF), Recombinant Protein (Cat# AAA20208)
HADHB, Polyclonal Antibody (Cat# AAA21286)
Predicted: Mouse, Rat
ATP5A1/ATP Synthase Alpha, Polyclonal Antibody (Cat# AAA21288)
Predicted: Mouse, Rat